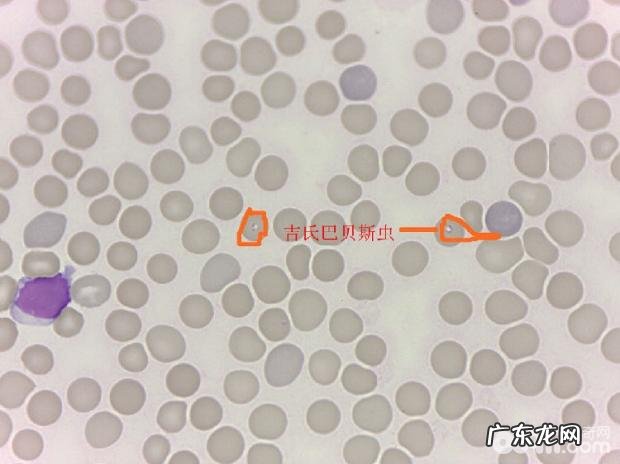
一例犬吉氏巴贝氏虫病例分析
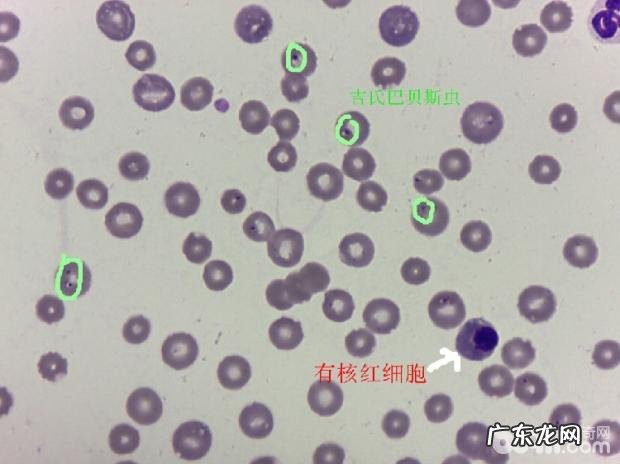
一例犬吉氏巴贝氏虫病例分析

巴贝斯虫是内寄生于血细胞内的疟原虫,内寄生犬的巴贝斯虫分成犬巴贝斯虫和吉氏巴贝斯虫 。二者均意谓蜱虫散播,内寄生于犬的血细胞中,导致患犬出現比较严重的缺铁性贫血及血红蛋白浓度的欠缺,进而严重危害小宠物生命健康 。
吉氏巴贝斯小虫体小,又叫巴士贝斯虫,直径在1-3 。3um 。虫体在血细胞内呈多形性,以斑点状,指环状及小杆状比较多见 。在法国上色和吉姆萨染色的血涂片上由此可见蓝紫色虫体 。我院近期问诊了一例患吉氏巴贝斯虫的病史,经医治病情好转,已经回家了服药并叮嘱按时复诊 。汇总以下:
一、小宠物基本资料:
小宠物名字:拉菲 。
宠物品种:比熊 。
小宠物年纪:三岁 。
小宠物性別:母(未绝育手术) 。
免疫系统彻底,除虫未做 。休重:2.9kg 。
二、主述:
十多天前突然冒出尿液颜色深红粘稠,精神实质胃口下降,那时候在合院查验重度贫血,以子宫蓄脓做生理性切除手术治疗,现创口恢复良好,精神实质胃口仍很差 。
三、临床医学查验:
实验室检查:
血常规检查重度贫血,RBC=1.08,HGB=26,HCT=0.091极其的缺铁性贫血 。MCV=88预兆脊髓再造工作能力优良 。血涂片发觉的很多虫体存有于血细胞中 。
文章插图
血涂片由此可见含有虫体的血细胞
文章插图
有核红细胞及很多含有虫体的血细胞

文章插图
血涂片中由此可见很多的网织红细胞
四、医治:
用药治疗:静脉注射,注入促血细胞生成素,打点滴消肿等 。
对因医治:注入贝尼尔机械纪元 。
五、转型期:
历经十几天的医治,小宠物状况早已转好,心跳修复,吃吃喝喝上厕所一切正常,回家了再次吃药 。
新项目
時间
标准值
12号
14号
16号
18号
20号
27号
RBC
1.08↓
1.15↓
1.78↓
2.64↓
2.78↓
4.22↓
5.5-8.5
HGB
26↓
30↓
4.7↓
6.7↓
6.8↓
9.5↓
12.0-18.0
HCT
0.095↓
0.12↓
17.4↓
23.5↓
23.8↓
32.1↓
37.0-55.0
MCH
24.1↓
26.1↑
26.4↑
25.4↑
24.5
22.5
19.5-25.5
MCHC
274↓
250↓
27↓
28.5↓
28.6↓
29.6↓
32.0-38.5
MCV
88↑
104.3↑
97.8↑
89↑
85↑
76
60.0-72.0
PLT
【一例犬吉氏巴贝氏虫病例分析】47↓
79↓
30↓
11↓
49↓
423
200-500
WBC
15
16.4
14
25↑
17
22.8↑
6.0-17.0
LYM
2.1
3
2.4
5
5.4
3
0.9-5.0
OTHR
12
10.5
11
16.3
10.4
18.1
0.3-1.5
EO
0.9↑
2.9↑
0.6
3.7↑
1.2↑
1.7↑
3.5-12.0

文章插图
一例犬吉氏巴贝氏虫病例分析
六、拓展阅读文章:
巴贝斯虫的生活史务必要根据2个寄主来进行,而现阶段科学研究的結果是蜱虫是唯一其孰知的终末宿主 。其生长发育共要历经三个环节,在其中包含:裂殖生殖系统,配子生殖系统,孢子生殖 。
特别声明:本站内容均来自网友提供或互联网,仅供参考,请勿用于商业和其他非法用途。如果侵犯了您的权益请与我们联系,我们将在24小时内删除。
